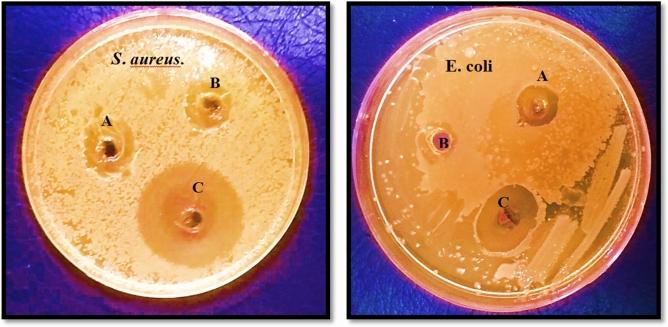
https://cdn.ncbi.nlm.nih.gov/pmc/blobs/d5e7/10516962/5db4a563efe9/41598_2023_42974_Fig6_HTML.jpg

新型磁性壳聚糖-镍铁氧体纳米复合材料的合成与表征及其抗菌和抗氧化性能。
Synthesis and characterization of a novel magnetic chitosan-nickel ferrite nanocomposite for antibacterial and antioxidant properties.
机构信息
Department of Environmental Health, Food Safety Division, School of Public Health, Tehran University of Medical Sciences, Tehran, Iran.
Department of Pharmaceutical Biotechnology, Faculty of Pharmacy, Tehran University of Medical Sciences, Tehran, Iran.
出版信息
Sci Rep. 2023 Sep 22;13(1):15777. doi: 10.1038/s41598-023-42974-6.
A novel nanomagnet modified with nickel ferrite nanoparticles (NPs) coated with hybrid chitosan (Cs-NiFeO) was synthesized using the co-precipitation method. The resulting nanomagnets were characterized using various techniques. The size of the nanomagnetic particles was estimated to be about 40 nm based on the transmission electron microscopy (TEM) image and X-ray diffraction analysis (XRD) pattern (using the Debye-Scherrer equation). Scanning electron microscopy (SEM) images indicated that the surface of Cs-NiFeO NPs is flatter and smoother than the uncoated NiFeO NPs. According to value stream mapping (VSM) analysis, the magnetization value of Cs-NiFeO NPs (17.34 emu/g) was significantly lower than NiFeO NPs (40.67 emu/g). The Cs-NiFeO NPs indicated higher antibacterial properties than NiFeO NPs and Cs. The minimum inhibitory concentrations of Cs-NiFeO NPs against S. aureus and E. coli were 128 and 256 mg/mL, respectively. Antioxidant activity (evaluated by 2,2-diphenyl-1-picrylhydrazyl (DPPH) scavenging test) for NiFeO NPs and Cs-NiFeO NPs at the concentration of 100 µg/mL were 35% and 42%, respectively. Consequently, the synthesized Cs-NiFeO NPs can be proposed as a viable material for biomedical applications.
一种新型纳米磁体,通过共沉淀法用镍铁氧体纳米粒子(NPs)涂覆的混合壳聚糖(Cs-NiFeO)进行修饰。使用各种技术对得到的纳米磁体进行了表征。基于透射电子显微镜(TEM)图像和 X 射线衍射分析(XRD)图谱(使用德拜-谢勒方程),纳米磁性颗粒的尺寸估计约为 40nm。扫描电子显微镜(SEM)图像表明,Cs-NiFeO NPs 的表面比未涂层的 NiFeO NPs 更平坦、更光滑。根据价值流图(VSM)分析,Cs-NiFeO NPs 的磁化值(17.34 emu/g)明显低于 NiFeO NPs(40.67 emu/g)。Cs-NiFeO NPs 表现出比 NiFeO NPs 和 Cs 更高的抗菌性能。Cs-NiFeO NPs 对金黄色葡萄球菌和大肠杆菌的最小抑菌浓度分别为 128 和 256mg/mL。在浓度为 100μg/mL 时,NiFeO NPs 和 Cs-NiFeO NPs 的抗氧化活性(通过 2,2-二苯基-1-苦基肼(DPPH)清除试验评估)分别为 35%和 42%。因此,合成的 Cs-NiFeO NPs 可作为生物医学应用的一种可行材料。